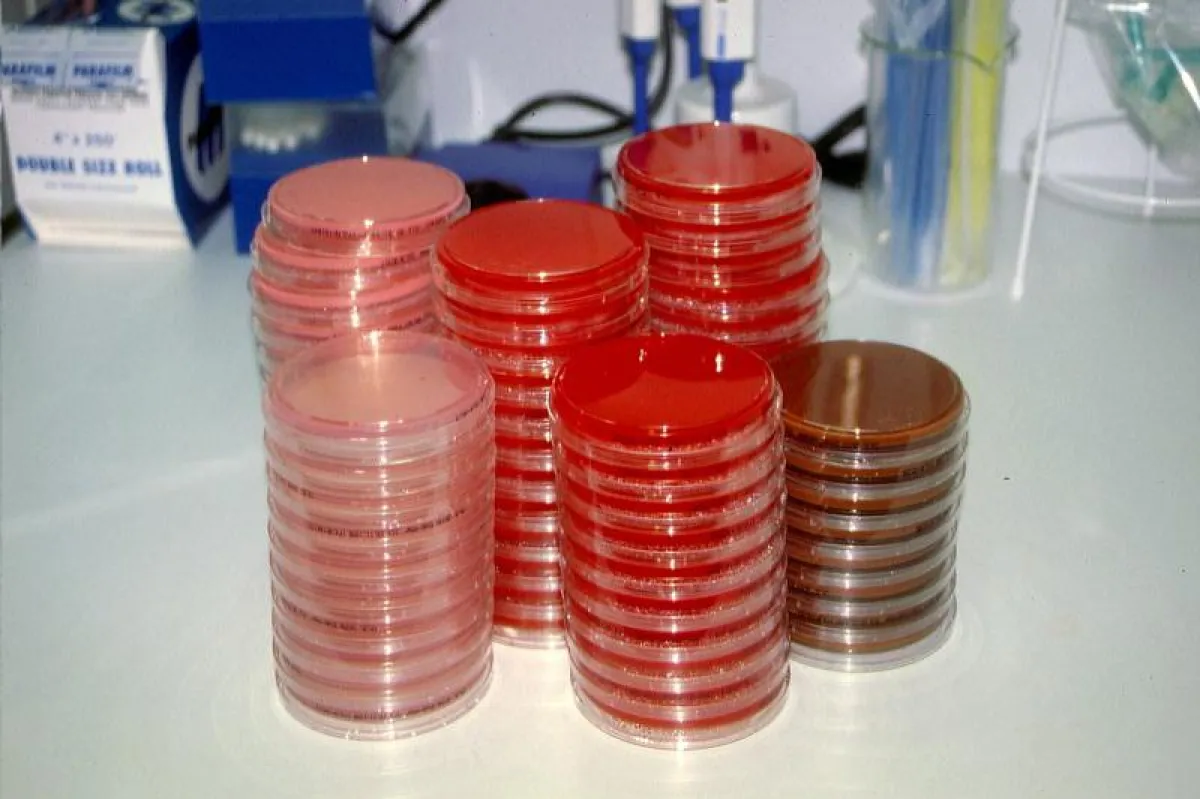
Petrischalen für die Impfung mit  Bakterienkulturen

(openPR) Jeder redet über Glyphosat: die einen warnen z.B. wegen des Krebsrisikos und der negativen Auswirkungen bei Bienen und anderen Insekten, davor, andere widersprechen dem, und selbst die Bundesanstalt für Risikobewertung (BfR) gibt bei der Bewertung von Glyphosat „grünes Licht“. „Ein Krebsrisiko bestehe bisher nicht“. Das BfR sieht also keinerlei Gefahren durch Glyphosat für die Gesundheit von Mensch und Tier und unterstützt die Nachzulassung.
Was anscheinend bisher noch gar nicht beachtet wurde, dass Glyphosat wahrscheinlich auch für die Entstehung von Antibiotikaresistenzen in Zusammenhang gebracht werden kann.
Bakterien können über verschiedene Mechanismen resistente Klone entwickeln, wenn sie dem Selektionsdruck von Antibiotika und Bioziden (z. B. Desinfektionsmittel, Herbizide) ausgesetzt sind. Die Aktivität von Bioziden und Antibiotika gegen Gram-negative Organismen kann durch Permeabilisierer, wie sie in Glyphosat-haltigen Herbizidformulierungen enthalten sind, gesteigert werden. Neben antibiotischen und bioziden Resistenzen können Bakterien auch Resistenzen zu toxischen Substanzen in der Umwelt entwickeln, die im Boden, Wasser, Nahrung oder Futtermitteln vorkommen. Einige dieser Substanzen werden in der modernen Landwirtschaft verwendet, wie z. B. Glyphosat-haltige Herbizide. Glyphosat-Resistenz konnte auch bei Geflügel-Isolaten von Salmonella Typhimurium, S. Enteritidis und S. Gallinarum festgestellt werden. Beziehungen zwischen Antibiotika-Resistenzen und Resistenzen für andere toxische Substanzen sind beschrieben, die auch Untersuchungen von Prof. Dr. Monika Krüger aus Leipzig bestätigt wurden. Die Wissenschaftlerin wies bei multiresistenten Enterobakterienisolate (ESBL) von Patienten auch Glyphosatresistenen nach. Von neun resistenten Mutanten war eine Mutante auch resistent für Ampicillin/Sulbactam, Piperacillin und Streptomycin.
Ist Glyphosat auch mit verantwortlich von Antibiotikareststenzen? Diese Frage bedarf schnellstmöglicher Klärung, um Gesundheit von Mensch und Tier nicht aufgrund einer zusätzlichen Entstehung antibiotikaresistenter Keime mittels Glyphosat zu forcieren. Dies fordert nicht nur der Gründer und Leiter der Agrar- und Veterinär- Akademie (AVA), Agrarwissenschaftler und Fachtierarzt Ernst-Günther Hellwig, aus dem münsterländischen Horstmar-Leer. In einem Beitrag von Frau Prof. Dr. Monika Krüger aus der Schriftenreihe der Agrar- und Veterinär- Akademie (AVA), der NUTZTIERPRAXIS AKTUELL (NPA), Nr. 54, Juni 2016,( Ist Glyphosat eine der Ursachen für die Entstehung multiresistenter Bakterien?) wurde auf diese möglichen Zusammenhänge hingewiesen.
Schlüsselwörter:
Glyphosat, Antibiotikaresistenz, One Health, AVA, Agrar- und Veterinär- Akademie, Hellwig, Veterinärmedizin, Tiergesundheit, Antibiotika, Nutztierpraxis Aktuell, Monika Krüger, Bundesanstalt für Risikobewertung, BfR